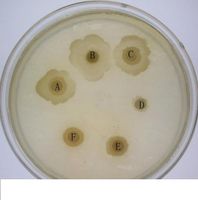
蛆蟲療法

療法歷史
蠅的幼蟲——
蛆對感染創口的清潔作用很早就引起人們的注意。在十六世紀中葉就已發現感染創面上孳生的蠅蛆非但不會加重感染,反而有利於癒合。
在19世紀,
拿破崙的軍隊里使用這個方法為受傷的士兵治療,並且將這個方法推廣到了
美國內戰和
第一次世界大戰時期。
20世紀40年代,
抗生素的出現使得蛆治療法被遺棄,用蛆治病成了一種簡陋而不科學的土方法。在
美國和
歐洲一些國家蛆療被廣泛套用於各種化膿性感染的創面,包括:膿腫、燒傷、壞疽和慢性腿部潰爛,取得了良好的臨床效果,臨床治療率達80%。
21世紀,由於濫用抗生素導致耐藥菌出現,新一代醫生開始減少對抗生素的使用,重新青睞自然生物療法,又使蛆蟲療法回到了人們的視線。
國內王江寧教授於1998年將此療法引入國內,並套用於臨床獲得成功,嚴重軟組織感染合併全身中毒症狀的
 蛆蟲療法
蛆蟲療法病人可以不用截肢,既保全了生命又避免了截肢。中央電視台《走進科學》節目兩次報導了該療法的有效性。該項研究分別于于2004年、2010年兩次獲得國家自然基金資助;於2009年獲得北京首都醫學特色項目資助,從分子水平揭示了生物清創的本質及蛆蟲抗菌肽的分子結構及生物合成,為人類生物清創奠定更堅實的理論基礎,2010年《生物清創的臨床及實驗研究》項目獲得了北京市科技進步三等獎,生物清創的臨床適應症主要為:糖尿病足、褥瘡和創傷引起的軟組織感染。
療法優勢
醫用蛆是指一種特殊蠅種(
絲光綠蠅)的幼蟲,醫用蛆蟲清創傷口既快又好。首都醫科大學王江寧教授及454醫院王愛萍醫生臨床研究證明,該療法比傳統方法更能有效地清除傷口腐肉,加快潰瘍傷口的癒合,從而避免患者因肢體潰爛而進行截肢手術。蛆蟲療法治療糖尿病、足潰爛、皮膚潰爛等有一定優勢。
蛆蟲不會吃傷口周圍健康的組織,只攻擊創面上的壞死組織部分,不影響周圍正常組織,並能促進肉芽組織的形成。
它還可以進入到外科手術都難以到達的深部創面,它們在吞噬腐肉後的排泄物中含有殺菌的鹽,體內還有抗生素和提高患者免疫力等有助於潰瘍傷口癒合的物質。
實驗研究
王江寧教授所獲國家自然基金項目研究內容如下:
作用機理:
(1)蛆的分泌液能夠破壞不健康或異常組織, 而對健康組織無損。由於蛆蟲產生的膠原酶、類胰蛋白酶、類糜蛋白酶能將壞死組織分解成半液狀泡沫, 然後進行消化,此外它們的分泌液含有抗微生物的抗菌酞。
(2)蛆蟲能清除創面的細菌。它們有快速大量吞食消化細菌的能力。
(3)蛆蟲能刺激傷口癒合。有人在實驗中發現蛆蟲蠕動的機械刺激能促使成纖維細胞產生膠原和纖維 蛋白, 加速肉芽組織的生成。
(4)蠅蛆分泌鹼性物質,改變創面酸鹼度。
(5)其他
實驗一
活體蛆蟲分泌物的抑菌作用研究
一、活體蛆蟲的無菌處理
我們的方法是於餵養的2-3天取出蛆蟲。先用生理鹽水反覆沖洗,將幼蟲分別放在3.5%甲醛生理鹽水溶液中5分鐘;放入2%的雙氧水溶液中3分鐘;放入5%的碘仿溶液中;放入5%的含氯的消毒液中;放入75%的酒精中3分鐘,不影響蛆的生活力。我們設計連續用以上濃度的甲醛、雙氧水和含氯的消毒液對蛆進行處理,每次處理完畢後用蒸餾水洗滌,對消毒的蛆體表面經細菌和病毒學檢驗證實無細菌和病毒存在並且蛆的活力仍然存在,無菌狀態可用於活體臨床與基礎實驗。
二、活體蛆蟲分泌物的獲取
取適量蛆蟲(600條),分為金葡菌誘導組(將300條幼蟲與金葡菌共培養48小時)和對照組,分別加入2倍體積TNE緩衝液(10 mM Tris-HCl, pH 7.5 ,150 mM NaCl, 5 mM EDTA,及蛋白酶抑制劑混合物含10µg/ml leupeptin,1µg/ml aprotinin,and 1mM PMSF,3mM Na3VO4)冰浴10min,充分勻漿勻漿液離心(12000Xg,4OC,10min) 取上清液,加3倍體積的TNE緩衝液,沸水浴2min離心(12000Xg, 4OC,10min)取上清液,即為粗提物。
三、抗菌物質生物活性測定方法的建立
細菌濃度及培養基對抑菌斑形成的影響:研究發現不同細菌濃度及培養基對抑菌斑的形成及菌斑大小有明顯作用,經過選擇我們使用能使抗菌物質產生最大抑菌斑的細菌濃度即5個OD值,30ul來鋪平板,並用水解酪蛋白做為固體培養基便於純化過程中更敏感地檢測抗菌物質生物活性。 不同細菌對於抗菌物質的抗菌敏感性比較:比較了兩種不同細菌革蘭氏陽性菌(金黃色葡萄球菌)和革蘭氏陰性菌(大腸桿菌)對抗菌物質的抗菌敏感性,結果如圖示
蛆蟲療法
蛆蟲療法 蛆蟲療法
蛆蟲療法A,B,C:抗菌粗提物 A,D:抗菌粗提物 E,F:幼蟲勻漿上清液
E,C:幼蟲勻漿上清液 D:TNE緩衝液 B:TNE緩衝液
四、總結
潰瘍創面繼發細菌感染是糖尿病足患者導致截肢的主要原因。抗生素治療具有局部濃度高的優點,但局部套用容易導致細菌耐藥,本實驗中頭孢哌酮對從臨床分離培養出的金黃色葡萄球菌的抗菌作用較弱證明了這一點。昆蟲具有特殊的免疫防禦體系,多種昆蟲受到外界有害刺激誘導時能產生體液免疫物質。蒼蠅幼蟲生活在病原微生物較多的環境中,但它自身則不得病,可見蠅體自身具有獨特的免疫防禦體系。實驗中採集的蛆蟲血淋巴分泌物提取液對金黃色葡萄球菌具有較強的抗菌作用,其抗菌能力強於頭孢哌酮。我們認為有害細菌在一定程度上起到了誘導作用,刺激蛆蟲的機體防禦體系產生抵抗這種細菌的物質。絲光綠蠅幼蟲(蛆)主要生長在腐屍和腐爛的魚肉等含有大量細菌的環境中,以腐敗組織為食物,對有血運的活體組織無任何影響。國外一些學者利用絲光綠蠅幼蟲的這一特性將其套用於感染創面的修復治療中,取得良好效果。我們將具有活力的蛆蟲蟲體消毒處理後,對蛆蟲體表經細菌和病毒學檢驗證實無細菌和病毒存在,將消毒的蛆蟲用於糖尿病足部潰瘍創面的臨床治療,所有病例創面膿性壞死組織清除乾淨,新鮮的肉芽組織迅速生長,創面表面培養無細菌。我們認為,蛆蟲在潰瘍創面上爬行,吞食膿性壞死組織、清潔創面的同時,環境中的金黃色葡萄球菌也進入蛆蟲體內,刺激蛆蟲機體產生某種抗菌蛋白物質,消滅細菌。
實驗二
活體蛆蟲分泌物促進糖尿病大鼠的創面癒合作用研究
一、材料與方法
1、糖尿病模型複製
:3月齡雄性普通級SD大鼠,體重300~350g,購自大連醫科大學實驗動物中心。實驗前12h禁食,定量。實驗當日稱體重,尾靜脈採血,用血糖儀測定基礎血糖,然後,給實驗組30隻75mg/kg注射鏈脲佐菌素(Sigma,臨用前溶解在0 01mmol/L的枸櫞酸緩衝液中,pH4 2),其餘大鼠給予等劑量枸櫞酸緩衝液腹腔注射。1周后當動物血糖濃度≥16.7mmol/L時,糖尿病模型複製成功。
2、創面模型製作
:取上述人工複製的糖尿病大鼠20隻和正常組大鼠10隻,以5%鹽酸氯胺酮注射液(50mg/kg)腹腔推注麻醉後,背部剃毛,常規消毒。在無菌條件下用特製打孔器在鼠背中部脊柱上下兩處各打一圓孔,深至皮下,直徑1.8cm,創面面積為2.54cm2。止血後以無菌紗布包紮,單籠餵養,定量飲水與餵食。所有實驗均在清潔級動物實驗室完成。
3、中藥生肌膏配置:由生黃芪、炮甲、熟地、金銀花、黃連等十五味中藥組成,具有托里生肌、解毒化瘀之功效,由大連大學附屬醫院中藥房提供。
4、實驗分組:分為中藥治療組(TLSJ+DM)餵以中藥生肌膏3ml/只/d;單純蛆療組(MDT+DM) 、正常對照組(NORM)和模型對照組(DM) 均餵以生理鹽水 3ml/只/d。每日分別以蛆分泌物、生理鹽水各1.5ml 濕敷中藥治療組,單純蛆療組創面,上部創面濕敷蛆分泌物、下部創面濕敷生理鹽水。用無菌紗布復蓋,繃帶包紮並固定。單籠餵養。每日定時換藥 1 次至創面癒合。
二、觀測指標
1、癒合標準:天平稱重後換算成創面平面面積。測得的數據均用 x±s 表示,創面癒合標準為痂殼小於創面面積 5%或癒合面積≥95%為完全癒合。
2、病理學檢查:術後 7、14、21 天取各組動物創面組織,10%福馬林液固定標本,石蠟包埋切片後常規 HE 染色。
3、免疫組化
:各組的 bFGF、CTGF 的水平於術後 7、14、21 天取各組動物創麵皮緣,約 0.5×0.5cm2。用 SABC 免疫組化法分別檢測組織切片後,切片用二甲苯、梯度酒精脫蠟至水,PBS(0.01M)洗3分鐘 2 次,在室溫下 3%H2O2孵育切片 15 分鐘消除過氧化物酶,PBS 洗 3 分鐘 2 次,微波爐抗原修復 100℃10 分鐘,加動物血清封閉液封阻 10 分鐘,傾去,37℃下加入稀釋後的一抗工作液,4℃濕盒中過夜,PBS 洗 3 分鐘 3 次,加生物素化二抗工作液,37℃濕盒中溫育 20 分鐘,度酒精脫蠟至水,PBS(0.01M)洗3分鐘 2 次,在室溫下 3%H2O2孵育切片 15 分鐘消除過氧化物酶,PBS 洗 3 分鐘 2 次,微波爐抗原修復 100℃10 分鐘,加動物血清封閉液封阻 10 分鐘,傾去,37℃下加入稀釋後的一抗工作液,4℃濕盒中過夜,PBS 洗 3 分鐘 3 次,加生物素化二抗工作液,37℃濕盒中溫育 20 分鐘,PBS 洗 3 分鐘 3 次,加 SABC 酶標,37℃濕盒中溫育 20 分鐘,PBS 洗 3 分鐘三次,DAB 顯色,鏡下控制,顯色完成後入 PBS 終止顯色,流水沖洗 10 分鐘,蘇木素復染30 秒,流水返藍 10 分鐘,脫水,透明,封固,中性樹膠封片。每張切片在10×20倍顯微鏡下隨機選取創傷皮膚內的4個不重疊的視野,進行 bFGF 陽性表達細胞, CTGF 陽性表達細胞計數。
三、數據處理方法以均數±標準差表示,同組治療前後採用配對 t 檢驗,組間比較採用單因素方差分析,用 SPSS10.0 對數據進行統計分析。
四、結 果
1.一般觀察:造模 1 周時,造模大鼠均出現飲水量、尿量、攝食量增多,並表現出反應遲緩和倦怠,毛色無光澤。實驗結束時,正常對照組大鼠活潑好動,毛色光澤,攝食正常,創面基本自行修復。模型對照組大鼠全身明顯消瘦及飲水量、尿量加重,創面滲出、糜爛嚴重,創面不斷加大加深,其他情況無改善。中藥治療組大鼠毛色尚有光澤,體重及飲水量無明顯減少,活動頻率如常,攝食尚可,創面恢復如新。單純蛆療組大鼠毛色無光澤,活動較前稍有增加,創面恢復,但形成的皮膚組織較薄。中藥治療組明顯優於模型對照組及單純蛆療組。血糖變化除正常對照組,其他各實驗組各時間點,血糖值經單因素方差分析發現組間無顯著性差異(P>0.05), 所以可以不考慮各組間血糖值影響傷口癒合的因素。
2.創口面積及創面癒合時間變化:傷後模型組創面面積逐漸增大,並且伴有潰爛、滲出,大鼠死亡率較高。蛆分泌物組及托里生肌中藥組早期創面癒合速度較慢,各組間無顯著性差異 P>0.05;至傷後第 7~21日,兩組創面明顯縮小。
靜脈性潰瘍患者參與了此項新研究。在住院兩周期間,研究人員隨機挑選患者,分成兩組,每組超過50人,一組接受蛆蟲療法,一組接受傳統的手術刀清理傷口療法。治療時,兩組患者均被蒙上眼睛,並不知道自己接受的是何種療法。
治療使用的蛆蟲是絲光綠蠅幼蟲,裝在小瓶子裡,治療時放在患者傷口上,一周兩次。蛆蟲分泌的物質滲入傷口,溶解死亡的組織而後吃掉,在它們的內臟進行進一步降解。
法國卡昂大學醫學中心的安妮-多姆馬丁博士和同事表示,兩組患者在疼痛或者感受到的蠕動感方面沒有差異。他們的研究發現刊登在《皮膚病學文獻》上。
一周后,接受外科手術清理傷口的患者傷口處平均有三分之二的區域被腐肉復蓋,腐肉會阻礙傷口癒合。相比之下,接受蛆蟲療法的患者只有55%的傷口區域被腐肉復蓋。
專家說法
研究顯示蛆蟲除了能夠清理傷口外,還具有潛在的抗菌和治療功效,但並非所有研究人員都相信這一點。美國邁阿密大學醫學院的羅伯特-克里斯納博士指出,這種療法也存在劣勢。他說:“接受這種療法的患者在心理上必須非常強大。”
研究發現,使用蛆蟲帶來的益處在兩周后消失,傷口閉合情況與手術療法沒有差異。英國曼徹斯特大學研究蛆蟲處理傷口的護理學教授尼克-庫魯姆表示:“如果臨床醫生和患者的主要目的是讓傷口癒合,蛆蟲似乎並不會帶來任何益處,因此並不是一個理想的選擇。我們此前進行的研究就已經發現蛆蟲清理傷口的速度超過傳統治療手段,但在讓傷口癒合方面並沒有任何優勢。”
雖然法國患者在接受治療時只經受“輕度痛苦”,但庫魯姆表示參與她的研究的患者卻經常抱怨稱感受到“劇烈疼痛”。她說:“在實際臨床治療中,患者很清楚自己接受的是不是蛆蟲療法,我們測量到的疼痛感可能就是在臨床治療時使用蛆蟲後患者切身感受到的痛苦。”2004年起,英國批准蛆蟲用於醫療用途。法國研究人員和庫魯姆均表示,蛆蟲可能在治療植皮創傷方面發揮作用,但庫魯姆警告稱研究尚未證實這一點。

